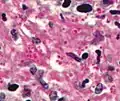

هیستوپلازما کپسولاتوم
هیستوپلازما کپسولاتوم (به انگلیسی: Histoplasma capsulatum) یک گونه از قارچهای دیمرفیک است.
| هیستوپلازما کپسولاتوم | |
|---|---|
 | |
| Histoplasma (bright red, small, circular). PAS diastase stain | |
| آرایهشناسی | |
| فرمانرو: | قارچها |
| دسته: | Ascomycota |
| رده: | Eurotiomycetes |
| راسته: | Onygenales |
| تیره: | Ajellomycetaceae |
| سرده: | Histoplasma |
| گونه: | H. capsulatum |
| نام علمی | |
| Histoplasma capsulatum Darling (1906) | |
طیف بیماریزایی
هیستوپلازموزیز معمولاً از نظر بالینی عفونتی خفیف میباشد، و اغلب شخص مبتلا حتی متوجه وجود عفونت نمیشود. این قارچ میتواند در ریهها زنده بماند، و زمانی که فرد دچار ضعف ایمنی میباشد دچار بیماری کند. هیستوپلازموز را میتوان اغلب به عنوان عفونت حاد ریوی مشاهده کرد، و علائم بالینی آن شبیه به ذات الریه حاد است، با این تفاوت که بدون درمان در اغلب موارد درمان میشود. این عفونت در کودکانی که به تازگی در معرض هیستوپلازما قرار گرفتهاند دیده میشود.
تصاویر اضافی
 H. capsulatum. Methenamine نقره ای رنگ.
H. capsulatum. Methenamine نقره ای رنگ. Histoplasma. پاس diastase لکه.
Histoplasma. پاس diastase لکه. Histoplasma در granuloma. پاس diastase لکه.
Histoplasma در granuloma. پاس diastase لکه. Histoplasma در granuloma. GMS لکه.
Histoplasma در granuloma. GMS لکه.
منابع
- مشارکتکنندگان ویکیپدیا. «Histoplasma capsulatum». در دانشنامهٔ ویکیپدیای انگلیسی، بازبینیشده در ۱۹ سپتامبر ۲۰۱۸.
| در ویکیانبار پروندههایی دربارهٔ هیستوپلازما کپسولاتوم موجود است. |
This article is issued from Wikipedia. The text is licensed under Creative Commons - Attribution - Sharealike. Additional terms may apply for the media files.
